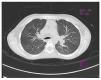

Introducción: El síndrome hepatopulmonar es una complicación rara caracterizada por enfermedad hepática asociada con dilataciones vasculares intrapulmonares e hipoxemia. La prevalencia reportada en los escasos estudios realizados en niños con cirrosis es del 3-8%. Aunque es una entidad poco frecuente, es de suma importancia que el clínico la reconozca debido a su curso progresivo.
Caso clínico: Se presenta el caso de una niña de 8 años de edad con diagnóstico de cirrosis hepática e hipertensión portal, con sintomatología de disnea y cianosis. Al examen físico se encontró desnutrida, con ictericia generalizada, telangiectasias en abdomen, hipocratismo digital severo, acrocianosis, platipnea y ortodeoxia. La gasometría arterial con PaO2 de 59 mmHg. El ecocardiograma con test de suero salino agitado resultó positivo y la gammagrafía de perfusión pulmonar con macroagregados de albúmina reportó cortocircuito derecha a izquierda del 15%, demostrándose así la existencia de shunt intrapulmonar. Se integró el diagnóstico de síndrome hepatopulmonar de severidad grave, y se recomendó trasplante hepático como el único tratamiento eficaz.
Conclusiones: En niños con enfermedad hepática que presenten disnea e hipoxemia, y en los que estén en protocolo de trasplante hepático, debe de buscarse intencionadamente el síndrome hepatopulmonar, ya que el pronóstico dependerá del diagnóstico oportuno.
Background: Hepatopulmonary syndrome is a rare complication characterized by liver disease associated with hypoxemia and intrapulmonary vascular dilatations. The prevalence reported in the few studies in children with cirrhosis is 3-8%. Although uncommon, it is important for physicians to recognize this condition because of its progressive course.
Case report: We report the case of an 8-year-old girl diagnosed with liver cirrhosis and portal hypertension with symptoms of dyspnea and cyanosis. On physical examination the patient was found malnourished with jaundice, telangiectasias in abdomen, severe clubbing, acrocyanosis, platypnea and orthodeoxia; arterial blood gas showed PaO2 of 59 mmHg. Echocardiography with agitated saline test was positive and lung perfusion scan with albumin macroaggregates reported 15% right-to-left short circuit, thus demonstrating the existence of intrapulmonary shunt. Diagnosis of severe hepatopulmonary syndrome was made. Liver transplantation is recommended as the only effective treatment.
Conclusions: In children with liver disease presenting dyspnea and hypoxemia and those enrolled in a liver transplant protocol, hepatopulmonary syndrome must be intentionally searched because the prognosis will depend on timely diagnosis.
Pagina nueva 1 1. Introduction
Hepatopulmonary syndrome is a rare complication characterized by liver disease associated with intrapulmonary vascular dilatations and hypoxemia.1 A prevalence of 9-20% has been described in children associated with biliary duct atresia, 0.5% in patients with portal thrombosis2 and 2-8% in cirrhosis and portal hypertension.2,3 Although the condition is uncommon, it is important that the clinician recognizes this disease due its progressive nature.
2. Clinical case
We report the case of an 8-year-old girl without significant perinatal or respiratory history. At 3 of years of age she was diagnosed with liver cirrhosis of unknown etiology. She was hospitalized on multiple occasions due to upper gastrointestinal (GI) bleeding from large esophageal varices. She also had portal hypertension. She was under treatment with furosemide, spirinolactone, propanolol, omeprazole, lactulose and liver transplant protocol for which she presented to the pulmonary service for pre-transplant evaluation.
During the family interview, it was reported that the patient had 7 months of ungual growth of the fingers and cyanosis associated with dyspnea during moderate exertion (walking three blocks) for the past 15 days. She denied cough, wheezing or rhonchi. On physical examination the patient was malnourished with generalized icterus, severe digital clubbing and acrocyanosis. On auscultation no pathological sounds were found in the lung fields. A collateral venous network was seen in the abdomen. There was no ascites. Hepatomegaly of 3 cm and splenomegaly of 10 cm below the costal margin were observed.
Platypnea was found (increase in dyspnea when in the seated position that improves with dorsal decubitus position) and positive orthodeoxia (oxygen saturation of 79% in room air in the Fowler position and of 84% in the decubitus supine position). Based on these findings, arterial blood gas study was done (with an FiO2 21%), which showed pH 7.46, PaCO2 22.6 mmHg, PaO2 59 mmHg, HCO3 16 mEq/l and base excess 7.1 mEq/l, SO2 92.6, PAO2 88.3 mmHg, alveolar-arterial difference 29.3 mmHg, and arterial-alveolar ratio 0.6. Results were interpreted as severe respiratory alkalosis and hypoxemia. Blood gases with 100% oxygen had the following values: pH 7.46, PaCO2 25.7 mmHg, PaO2 148.7 mmHg, HCO3 18.3 mEq/l and base excess 4.4 mEq/l; hyperoxia test was positive.a
Chest x-ray was normal (Fig. 1). Computed tomography (CT) of the chest demonstrated an increase in the hilar pulmonary vasculature (Fig. 2). Spirometry tests were with normal predicted values: FEV1/FVC ratio 88%, FEV1 84% and FVC 84% and plethysmograph was without changes.a
Figure 1 Antero-posterior chest x-ray in which parahilar enhancement is seen.
Figure 2 Tomography of the chest, axial cut, that shows vascular hilar dilatations.
The possibility of hepatopulmonary syndrome was raised due to the presence of chronic liver disease, hypoxemia and possible pulmonary shunt, which were confirmed with the echocardiogram of agitated serum saline in which bubbles were visualized in the left atrium in the third heartbeat. The heart was structurally healthy with normal right ventricular outlet pressure of 31 mmHg. Pulmonary perfusion scan with albumin macroaggregates labeled with Tc-99m reported a left to right shunt of 15%, with uptake of the radiotracer in the brain and kidneys (Fig. 3). On this basis, diagnosis of hepatopulmonary syndrome was established.
Figure 3 Pulmonary perfusion scan with albumin macroaggregates labeled with technetium-99m. Radiotracer activity in the brain and kidneys. Left to right shunt of 15%.
The severity was determined due to the PaO2 value of 59 mmHg and it was classified as type II according to the positive hyperoxia test. The patient remained on home oxygen as supportive therapy while the liver transplant was planned, which was recommended to be done promptly to avoid disease progression and a fatal outcome.
3. Discussion
Hepatocellular syndrome is defined as a triad that includes the following diagnostic criteria:
1. Liver disease with or without portal hypertension
2. Abnormalities in gas exchange (PaO2 <80 mmHg and alveolar-arterial difference >15 mmHg)
3. Pulmonary capillary vascular dilatation4,5
Development of hepatopulmonary disease is independent of the etiology of the liver disease. However, there are studies in which it is most associated with liver cirrhosis and portal hypertension (8-17%).1,4,6
Symptoms present in hepatopulmonary syndrome can be divided into hepatic and hypoxic. Hepatic symptoms include icterus, telangiectasias, hepatomegalies, ascitis, collateral circulation and edema of the extremities. Of the hypoxic symptoms described in the literature, dyspnea on exertion, platypnea, digital clubbing and cyanosis were found.5
Dyspnea has been described as a cardinal symptom for the suspicion of hepatopulmonary disease. Its onset is generally insidious and with exacerbation on exercise.7 In the series by Aguerre et al., it was the first symptom reported by patients.8 Although it is not a pathognomonic sign, the presence of platypnea is suggestive of the diagnosis.9
Digital clubbing, marked as a physical sign of hypoxemia, was notable in this patient because, according to the history, she had a 7-month evolution. However, its presence has been reported as an indicator of advanced disease.4,5
Aguerre et al. described that the duration of respiratory symptoms up to the time of diagnosis of hepatopulmonary syndrome could be 4.8 ± 2.5 years.8
Among the diagnostic tests for evaluation of hepatopulmonary syndrome are those mentioned below:
• Routine determination of oxygen saturation on room air via pulse oximetry as an easy and effective test to determine hypoxemia in patients to be transplanted10 (with saturations <94% considered to be abnormal)2. However, pulse oximetry within normal values does not rule out hepatopulmonary syndrome.8
• Orthodeoxia test has also been associated with hepatopulmonary syndrome. Its physiopathology continues to be insufficient and cut-off points have not yet been validated for its use as diagnostic criteria.4 However, it has been suggested that orthodeoxia is characterized by a decrease in the PaO2 ≥4 mmHg or to 5% from the supine decubitus position up to the standing position.2,11
• Arterial blood gases show respiratory alkalosis with hypoxemia. This finding is characteristic of hepatopulmonary syndrome caused by hyperventilation intended to compensate for the hypoxemia.2,8 Another abnormality is the increase in the alveolar-arterial difference of >15 mmHg,4 considered as an early marker of the disease.12 Based on these findings, the hyperoxia test is indicated and is carried out with the measurement of arterial blood gases of the patient while breathing room air. Blood gases are subsequently measured after the patient has breathed oxygen at 100% for 10 min. It is positive when PaO2 is maintained <150 mmHg,13 confirming the presence of the shunt.4
It is important to note that hypoxemia, a characteristic element of this syndrome,12 with the presence of alveolar-arterial difference >15 mmHg, allows for classifying the patients according to the level of severity: mild (with PaO2 >80 mmHg), moderate (PaO2 60-80 mmHg), severe (PaO2 50-60 mmHg) and very severe (PaO2 <50 mmHg).2,4 Based on these criteria, the patient was classified with severe hepatopulmonary syndrome (PaO2 59 mmHg). This classification is carried out in order to be able to identify liver transplant candidates with the poorest prognosis.11 With a PaO2 <50 mmHg, the risk of post-transplant mortality increases.12
Chest x-ray is described as normal in patients with hepatopulmonary syndrome.12,13 CT of the chest is indicated to exclude abnormalities in the pulmonary parenchyma causing hypoxemia.14 The presence of vascular dilatations4 can be seen, such as those found in this case. Functional spirometry and pulmonary volume study tend to be normal or mildly abnormal according to the lung restrictions.12
Among the diagnostic methods to demonstrate the presence of an intrapulmonary shunt are echocardiography with the agitated serum saline test, which is considered to be the gold standard, with a sensitivity of 68-75% and a specificity of 93-100%.14 It is positive if, after injection of 10 mL of agitated serum saline into a systemic vein, microbubbles appear in the right atrium, and after three to six cardiac cycles they are seen in the left atrium.2
Another method for confirming the presence of pulmonary vascular dilatations is the pulmonary perfusion scan using albumin microaggregates labeled with technetium-99m (99mTc MAA). This allows for quantifying the percentage of intrapulmonary dilatations based on a greater extrapulmonary uptake of the macroaggregates. It is considered pathologic when the values are ≥6%.15
In accordance with the previously mentioned diagnostic criteria, Krowka classified hepatopulmonary syndrome in the following manner:
• Type I (diffuse)—patients with precapillary dilatation who respond to 100% oxygen, achieving a PaO2 >200 mmHg;
• Type II (focal fistulas)—patients with localized vasodilatations, similar to an arteriovenous malformation, who have a poor response to the administration of 100% oxygen. These are the patients who present true shunts unable to attain a PaO2 >200 mmHg. It is less common than type I13,14
Currently there is no effective and useful medical treatment for management of hepatopulmonary syndrome.5 Liver transplantation is the only treatment that allows reversal of the hepatopulmonary syndrome,16 with success rates ranging between 70 and 84%6,8 (with the exception of very severe cases, with PaO2 <50 mmHg12, who demonstrate a mortality rate >30%3,15). Resolution of the pulmonary dilatation has been observed from 3 months post-transplantation.9
Home oxygen therapy has been used although there is insufficient evidence about its benefits. However, it is recommended in those patients with PaO2 <60 mmHg to avoid circulatory complications of hypoxemia and subjectively improve the quality of life for the patients11,12 while they await liver transplant.4 For this reason, it was indicated for the patient.
Poor prognostic factors are the PaO2 <50 mmHg breathing room air, shunt >20% on the scan with albumin macro-aggregates, severe pulmonary hypertension and positive hyperoxia test.3,15 However, one should take into account that the prognosis without a transplant is ominous, with a survival rate of 16-30% at 1 year from the time of diagnosis.12
Hepatopulmonary syndrome should be intentionally looked for in children with liver disease who present with dyspnea and hypoxemia and who are in a liver transplantation protocol because prognosis will depend on the timely diagnosis.17
Ethical responsabilities
Protection of human and animal subjects. The authors declare that no experiments were performed on humans or animals for this investigation.
Confidentiality of Data. The authors declare that no patient data appear in this article.
Right to privacy and informed consent. The authors declare that no patient data appear in this article.
Funding
None.
Conflict of interest
The authors declare no conflict of interest of any nature.
a FiO2: fraction of inspired oxygen; PaCO2: arterial pressure of carbon dioxide; PaO2: arterial oxygen pressure; HCO3: bicarbonate; PAO2: alveolar oxygen pressure; SO2: oxygen saturation; FEV1: forced expiratory volume in 1 second; FVC: forced vital capacity.
Received 16 January 2015;
accepted 24 April 2015
http://dx.doi.org/10.1016/j.bmhimx.2015.04.001
* Corresponding author.
E-mail:jessicasaenzgomez@yahoo.com (J. Sáenz-Gómez).